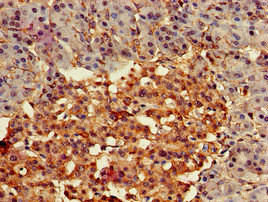

FZD4 Antibody
-
中文名稱:FZD4兔多克隆抗體
-
貨號:CSB-PA890755LA01HU
-
規(guī)格:¥440
-
圖片:
-
Immunohistochemistry of paraffin-embedded human pancreatic tissue using CSB-PA890755LA01HU at dilution of 1:100
-
Immunofluorescent analysis of PC-3 cells using CSB-PA890755LA01HU at dilution of 1:100 and Alexa Fluor 488-congugated AffiniPure Goat Anti-Rabbit IgG(H+L)
-
Western Blot
Positive WB detected in: Hela whole cell lysate
All lanes: FZD4 antibody at 3.5μg/ml
Secondary
Goat polyclonal to rabbit IgG at 1/50000 dilution
Predicted band size: 60 kDa
Observed band size: 60 kDa
-
-
其他:
產(chǎn)品詳情
-
產(chǎn)品名稱:Rabbit anti-Homo sapiens (Human) FZD4 Polyclonal antibody
-
Uniprot No.:
-
基因名:
-
別名:FZD4; Frizzled-4; Fz-4; hFz4; FzE4; CD antigen CD344
-
宿主:Rabbit
-
反應(yīng)種屬:Human
-
免疫原:Recombinant Human Frizzled-4 protein (37-222AA)
-
免疫原種屬:Homo sapiens (Human)
-
標(biāo)記方式:Non-conjugated
本頁面中的產(chǎn)品,F(xiàn)ZD4 Antibody (CSB-PA890755LA01HU),的標(biāo)記方式是Non-conjugated。對于FZD4 Antibody,我們還提供其他標(biāo)記。見下表:
-
克隆類型:Polyclonal
-
抗體亞型:IgG
-
純化方式:>95%, Protein G purified
-
濃度:It differs from different batches. Please contact us to confirm it.
-
保存緩沖液:Preservative: 0.03% Proclin 300
Constituents: 50% Glycerol, 0.01M PBS, pH 7.4 -
產(chǎn)品提供形式:Liquid
-
應(yīng)用范圍:ELISA, WB, IHC, IF
-
推薦稀釋比:
Application Recommended Dilution WB 1:200-1:5000 IHC 1:20-1:200 IF 1:50-1:200 -
Protocols:
-
儲存條件:Upon receipt, store at -20°C or -80°C. Avoid repeated freeze.
-
貨期:Basically, we can dispatch the products out in 1-3 working days after receiving your orders. Delivery time maybe differs from different purchasing way or location, please kindly consult your local distributors for specific delivery time.
-
用途:For Research Use Only. Not for use in diagnostic or therapeutic procedures.
產(chǎn)品評價(jià)
實(shí)驗(yàn)應(yīng)用:IF
樣品信息:人膀胱癌
稀釋比:1:100
產(chǎn)品評價(jià): 使用CSB-PA890755LA01HU抗體,進(jìn)行IF)檢測,檢測人膀胱癌樣本,樣本處理情況為羊血清封閉,其結(jié)果為陽性。(可見上傳圖片結(jié)果),評價(jià)優(yōu)。
By s老師
相關(guān)產(chǎn)品
靶點(diǎn)詳情
-
功能:Receptor for Wnt proteins. Most frizzled receptors are coupled to the beta-catenin (CTNNB1) canonical signaling pathway, which leads to the activation of disheveled proteins, inhibition of GSK-3 kinase, nuclear accumulation of beta-catenin (CTNNB1) and activation of Wnt target genes. Plays a critical role in retinal vascularization by acting as a receptor for Wnt proteins and norrin (NDP). In retina, it can be activated by Wnt protein-binding and also by Wnt-independent signaling via binding of norrin (NDP), promoting in both cases beta-catenin (CTNNB1) accumulation and stimulation of LEF/TCF-mediated transcriptional programs. A second signaling pathway involving PKC and calcium fluxes has been seen for some family members, but it is not yet clear if it represents a distinct pathway or if it can be integrated in the canonical pathway, as PKC seems to be required for Wnt-mediated inactivation of GSK-3 kinase. Both pathways seem to involve interactions with G-proteins. May be involved in transduction and intercellular transmission of polarity information during tissue morphogenesis and/or in differentiated tissues.
-
基因功能參考文獻(xiàn):
- This is the first study to report a group of patients with digenic familial exudative vitreoretinopathy (FEVR). In most affected eyes, the stage was more severe than stage 3. We speculate that the phenotype of FEVR is more severe in patients with digenic rather than monogenic variants of FEVR-related genes. PMID: 30097784
- FzM1.8 is an allosteric agonist of FZD4. In the absence of any WNT ligand, FzM1.8 binds to FZD4, promotes recruitment of heterotrimeric G proteins, and biases WNT signaling toward a noncanonical route that involves PI3K. In colon cancer cells, the FZD4/PI3K axis elicited by FzM1.8 preserves stemness and promotes proliferation of undifferentiated cells. PMID: 29293331
- FZD4 Tyrosine 250(2.39) is crucial for DVL2 interaction and DVL2 translocation to the plasma membrane. PMID: 28668722
- Accessory proteins in Frizzled (FZD) receptor complexes are thought to determine ligand selectivity and signaling amplitude. PMID: 28658627
- FZD4 was confirmed to be a downstream target of miR-505, and found to be up-regulated in cervical cancer patients. PMID: 28577497
- The screening of candidate genes namely NDP, FZD4 and TSPAN12 led to the identification of six major coding region variants in 36 ROP probands. PMID: 28982955
- Seven novel mutations found in this study have broadened the spectrum of mutations in FZD4 known to cause familial exudative vitreoretinopathy (FEVR), providing a deeper understanding of this disease. The results show that mutations in FZD4 are associated with the phenotypes of retinal folds or ectopic macula in FEVR PMID: 27555740
- Three affected individuals within a family with FEVR presented with variable disease severity. All three affected family members harboured mutation c.349T>C (p.Cys117Arg) in FZD4. PMID: 28211206
- The findings in this family support the concept that some mutated FZD4 alleles can be associated with recessive rather than dominant disease. PMID: 27668459
- novel role of let-7b/Fzd4 axis through wnt signaling PMID: 27510711
- FZD4 down-regulation leads to loss of WNT/beta-catenin signal activity and subsequently to reduced alveolar epithelial cell wound repair capacity and impaired expression of elastogenic components. PMID: 28245136
- his study showed that Let7b modulates the proliferation, invasiveness, and migration of liver cancer cell and reduces the proportion of cancer stem cells in liver cancer cell by inhibiting Wnt/beta-catenin signaling pathway via downregulated Frizzled4. PMID: 28671046
- Among the detected mutations, LRP5 accounted for the largest proportion with a mean mutation rate of 16.1% (5/31, 16.1%), followed by NDP (3/31, 9.7%), FZD4 (2/31, 6.5%), TSPAN12 (1/31, 3.2%), and KIF11 (1/31, 3.2%). All the novel changes were predicted to be pathogenic by a series of bioinformatics analyses. PMID: 28494495
- human FZD4 assembles-in a DVL-independent manner-with Galpha12/13 but not representatives of other heterotrimeric G protein subfamilies. PMID: 27458145
- Several novel mutations (missense, non-stop and insertion) were detected in the coding regions of FZD4, TSPAN12 and ZNF408 genes among the unrelated familial exudative vitreoretinopathy probands. The mutations in FZD4 and TSPAN12 were involved in autosomal dominant and autosomal recessive families and further validates the involvement of these gene in exudative vitreoretinopathy development. PMID: 27316669
- Two were novel mutations: p.E134* and p.T503fs of FZD4 lead to the loss of FZD4 activity. PMID: 26530129
- Letter: FZD4+ and FZD4- melanocytes were significantly lower in hair follicles of patients with rhododenol-induced leukoderma. PMID: 26277630
- These structural, biophysical and cellular data, map Fz4 and putative Lrp5/6 binding sites to distinct patches on Norrin, and reveal a GAG binding site spanning Norrin and Fz4 cysteine-rich domain. PMID: 26158506
- The relatively high prevalence of the p.[P33S(;)P168S] variant in ROP (retinopathy of prematurity) and intrauterine growth restriction suggests that it also may be a marker for increased risk of developing ROP and preterm birth. PMID: 26119001
- Mutations of FZD4 accounted for the largest proportion, which could be directly applied to the testing strategy to start with screening for FZD4 mutations. PMID: 26244290
- analysis of allosteric ligands of Frizzled4 PMID: 25751279
- Defective trafficking resulting in haploinsufficiency is a major cellular mechanism for several missense FEVR-causing FZD4 mutants. PMID: 24744206
- Six different nonsynonymous DNA variants are identified in the coding region of either the FZD4 gene (p.H69Y, p.R127H, and p.Y211H) or the LRP5 gene (p.R1219H, p.H1383P, and p.T1540M) in seven patients with advanced retinopathy of prematurity PMID: 23441120
- Five mutations have been found in the FZD4 gene in six Chinese families with familial exudative vitreoretinopathy. PMID: 23077402
- Genetic analysis revealed that all affected family members of one pedigree carried an exon 2 mutation of COL2A1, and in the second pedigree, all affected members carried an FZD4 mutation. PMID: 22574936
- miR-493 is a new tumor suppressor miRNA in bladder cancer and inhibits cell motility through downregulation of RhoC and FZD4. PMID: 22057916
- Frizzled 4 is a member of the Wnt signaling family that governs both stemness and invasiveness of glioma stem cells, and that it may be a major cause of GBM recurrence and poor prognosis. PMID: 21363911
- FZD4 mutation screening can be a useful tool especially in mild or atypical cases of familial exudative vitreoretinopathy & Germ-line mutations in FZD4 do not appear to be a common cause of Coats disease. PMID: 21097938
- The profile of the mutations obtained in FZD4 further illustrates the complexity of familial exudative vitreoretinopathy (FEVR)and provides a better understanding of the genotype-phenotype correlations. PMID: 20938005
- Results provide mechanistic insights to ERG oncogenesis in prostate cancer, involving activation of WNT signaling through FZD4, leading to cancer-promoting phenotypic effects, including EMT and loss of cell adhesion. PMID: 20713528
- Studies report 21 novel variants for FZD4, LRP5, and NDP. PMID: 20340138
- Mutations in the FZD4 gene in this group of premature infants supports a role for the FZD4 pathway in the development of severe retinopathy of prematurity. PMID: 20141357
- Functions in retinal angiogenesis. Mutations disrupts angiogenesis in vitreoretinopathy. PMID: 12172548
- High-resolution genotyping and haplotype analysis excluded FZD4 as the defective gene in a family previously linked to the EVR1 locus. PMID: 14737064
- Familial exudative vitreoretinopathy has mutations in a second gene at the EVR1 locus, low-density-lipoprotein receptor-related protein 5 (LRP5), a Wnt coreceptor PMID: 15024691
- Eight mutations have been identified in the FZD4 gene in a cohort of 40 unrelated patients with FEVR (familial exudative vitreoretinopathy) PMID: 15223780
- FZD4 mutations are associated with autosomal dominant familial exudative vitreoretinopathy PMID: 15370539
- A novel missense mutation in the FZD4 gene was identified in Japanese patients with FEVR (familial exudative vitreoretinopathy). PMID: 15488808
- mutations in the LRP5 and/or FZD4 genes may have roles in familial exudative vitreoretinopathy PMID: 15981244
- Mutations in FZD4 were observed in 5.6% of studied clinically diagnosed familial exudative vitreoretinopathy in Indian population. Could play vital role in pathogenesis and provide greater insight in to genotype/phenotypic functions of FZD4 gene. PMID: 17093393
- Fz4 expression may play a critical role in responses to Wnt signaling in the tumor microenvironment. PMID: 17386109
- sFRP-1 can interact with Wnt receptors Frizzled 4 and 7 on endothelial cells to transduce downstream to cellular machineries requiring Rac-1 activity in cooperation with GSK-3beta PMID: 18156211
- Homozygous state for the FZD4 gene is possibly involved in the severity of the familial exudative vitreoretinopathy phenotype PMID: 18161623
- Report activation of Wnt signalling in acute myeloid leukemia by induction of Frizzled-4. PMID: 19020754
- The clinical features in the three children and their relatives with a documented FZD4 mutation support the previous reports of a high degree of intrafamilial and interfamilial variability in familial exudative vitreoretinopathy (FEVR). PMID: 19172507
- Mutations occurring in the FZD4 gene affect patients diagnosed with both autosomal-dominant familial exudative vitreoretinopathy (AdFEVR) or retinopathy of prematurity (ROP) PMID: 20008721
顯示更多
收起更多
-
相關(guān)疾病:Vitreoretinopathy, exudative 1 (EVR1)
-
亞細(xì)胞定位:Cell membrane; Multi-pass membrane protein.
-
蛋白家族:G-protein coupled receptor Fz/Smo family
-
組織特異性:Almost ubiquitous. Largely expressed in adult heart, skeletal muscle, ovary, and fetal kidney. Moderate amounts in adult liver, kidney, pancreas, spleen, and fetal lung, and small amounts in placenta, adult lung, prostate, testis, colon, fetal brain and l
-
數(shù)據(jù)庫鏈接:
Most popular with customers
-
-
Phospho-YAP1 (S127) Recombinant Monoclonal Antibody
Applications: ELISA, WB, IHC
Species Reactivity: Human
-
-
-
-
-
-